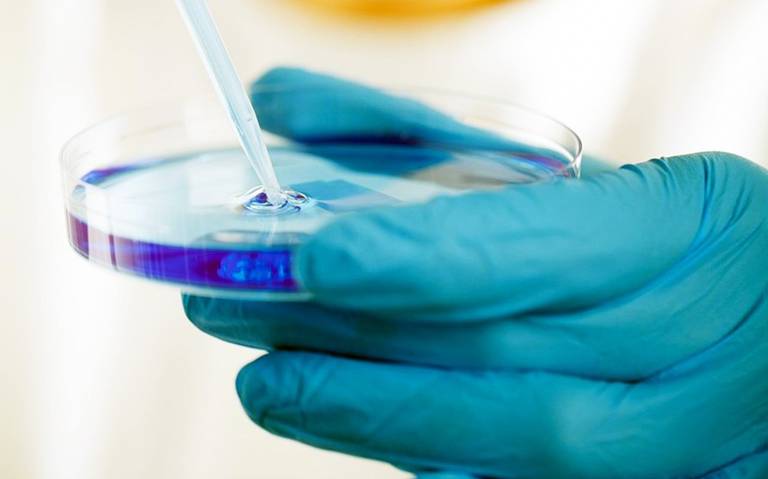

Una neoyorquina es la primera mujer posiblemente curada de VIH gracias a un trasplante de células madre de cordón umbilical resistentes a ese virus, que se combinaron con otras de un pariente cercano para aumentar las posibilidades de éxito.
La denominada paciente de Nueva York padecía además un tipo de leucemina, lo que hacía necesario un trasplante de médula, y lleva sin virus desde 2017, periodo que, por otros casos similares, se estima razonable para considerar que puede estar curada.
Este caso se dio a conocer hace un año en un congreso médico, pero hasta ahora no se habían publicado los resultados en ninguna revista científica, cosa que hace hoy en Cell el equipo, encabezado por la Universidad de California (UCLA) y la Johns Hopkins.
A día de hoy cuatro personas se consideran curadas del VIH, los pacientes de Berlín, Londres, Düsseldorf y ahora Nueva York. Todos padecían además una leucemia que requería de un trasplante de médula, una intervención arriesgada que solo está indicada en cánceres hematológicos.
El caso de la paciente de Nueva York, una mujer de mediana edad que se identifica como “racialmente mixta”, tiene varias peculiaridades frente a los otros, la primera que se sometió a un trasplante de células madre resistentes al VIH procedentes de sangre de cordón umbilical y no de un donante adulto compatible.
El equipo considera que el tratamiento ha dado “resultados satisfactorios a largo plazo”, indica el estudio, y que el uso de células madres de sangre de cordón umbilical aumenta la posibilidad de curar el VIH en personas de todos los orígenes raciales”.
Sin embargo, el uso de células de sangre de cordón umbilical “amplía las oportunidades para que las personas de diversa ascendencia que viven con el VIH y requieren un trasplante para otras enfermedades alcancen la curación”.
Los pacientes de Berlín, Londres y Düsseldorf recibieron trasplantes de células madre de adultos compatibles que portaban dos copias de la mutación CCR5-delta32, una mutación natural que confiere resistencia al VIH al impedir que el virus penetre en las células y las infecte.
Solo alrededor del 1 por ciento de las personas de raza blanca son homocigotas para la mutación CCR5-delta32 y es aún más rara en otras poblaciones, lo que limita la posibilidad de trasplantarlas a pacientes de color, ya que los trasplantes de células madre suelen requerir una gran compatibilidad donante y el receptor.
Estos condicionantes hacían casi imposible hallar un donante adulto con la citada mutación y compatible con la paciente, por lo que el equipo le trasplantó, en 2017, células madre portadoras de CCR5-delta32/32 de sangre de cordón umbilical almacenada para intentar curar simultáneamente el cáncer y el VIH.
Además, esas células se infundieron con células madre de uno de los familiares de la paciente para aumentar las probabilidades de éxito del procedimiento.
“Con la sangre del cordón umbilical no se dispone de tantas células y tardan un poco más en poblar el organismo tras su infusión”, pero usar una mezcla de células madre de un pariente y de sangre de cordón umbilical “da un empujón a las células de sangre de cordón umbilical”, indicó Bryson.
El trasplante consiguió poner en remisión tanto el VIH como la leucemia, la cual dura ya más de cuatro años. Treinta y siete meses después del trasplante, la paciente pudo dejar de tomar la medicación antivírica contra el VIH. Los médicos que hacen su seguimiento afirman que lleva más de 30 meses sin contraer el VIH desde que dejó el tratamiento antivírico (en el momento en que se redactó el estudio, solo habían pasado 18 meses).
Sin embargo, debido a lo invasivo del procedimiento, los trasplantes de células madre (tanto con la mutación como sin ella) solo se consideran para personas que necesitan un trasplante por otras razones, y no para curar de forma aislada el VIH, enfermedad para la que existe medicación.
El estudio destaca además la importancia de contar con células CCR5-delta32/32 en los trasplantes de células madre para pacientes con VIH, ya que todas las curaciones, hasta ahora, “han sido con esta población de células mutadas, y los estudios en los que se han trasplantado células madre nuevas sin esta mutación no han conseguido curar el VIH”, estacó Persaud.




Más historias
México sin casos de ébola; Secretaría de Salud refuerza vigilancia ante brote
Vence patente de Ozempic en India y abre paso a versiones genéricas más accesibles
Mujer perdió casi 30 centímetros de estatura por esta extraña enfermedad